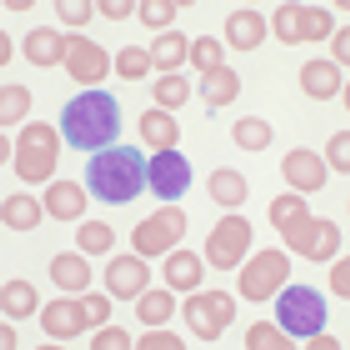

Treatment strategies for patients with myelodysplastic syndromes are built upon a foundation of supportive care, which consists of transfusions, iron chelation, and growth factor therapy.

Your AI-Trained Oncology Knowledge Connection!


Silas is the senior vice president, content, at MJH Life Sciences. He began his career at MJH in 2011 as a Web Editor on OncLive. From this role, he moved into managing the social media across the organization and then into broader roles across the content department, first taking on management of HCPLive.
Throughout his tenure at MJH, Silas has been accountable for several organic launches of highly successful brands, including Targeted Oncology and NeurologyLive, and for quickly transforming acquisitions into high-functioning business units. Follow him on X @SilasInman, LinkedIn, sinman@mjhlifesciences.com.

Treatment strategies for patients with myelodysplastic syndromes are built upon a foundation of supportive care, which consists of transfusions, iron chelation, and growth factor therapy.

HLA-matched allogeneic hematopoietic stem cell transplantation was associated with more than a doubling in 4-year overall survival rates for patients with intermediate-2 or high-risk myelodysplastic syndromes.

The first-in-class activin receptor antagonist sotatercept stimulated erythropoiesis in nearly half of patients with MDS and non-proliferative CMML following failure on erythropoiesis-stimulating agents.

Treatment with ofatumumab plus fludarabine and cyclophosphamide significantly improved progression-free survival compared with fludarabine and cyclophosphamide alone in patients with relapsed chronic lymphocytic leukemia.

A new drug application has been submitted for MM-398 in combination with 5-fluorouracil and leucovorin for patients with metastatic pancreatic cancer following prior treatment with a gemcitabine-based therapy.

The generics and specialty manufacturer Mylan has recalled several chemotherapy agents, including gemcitabine, carboplatin, methotrexate, and cytarabine, due to the presence of visible foreign particulates.

The FDA has approved second-line ramucirumab in combination with FOLFIRI as a treatment for patients with metastatic colorectal cancer (mCRC) following progression an upfront bevacizumab-containing regimen.

The FDA has updated the label for pomalidomide plus low-dose dexamethasone for multiple myeloma to include data from the phase III MM-003 study.

Treatment with the antibody-drug conjugate inotuzumab ozogamicin significantly extended complete hematologic remission rates compared with chemotherapy for adult patients with relapsed or refractory CD22-positive acute lymphoblastic leukemia,

The FDA has granted a breakthrough therapy designation to crizotinib as a potential treatment for patients with ROS1-positive non–small cell lung cancer.

The FDA has granted a priority review to the antibody-drug conjugate brentuximab vedotin as a consolidation therapy following autologous stem cell transplantation in patients with Hodgkin's lymphoma at risk of relapse or progression.

The PD-L1 inhibitor MPDL3280A demonstrated a 19% objective response rate (ORR) with 75% of responses ongoing in pretreated patients with metastatic triple-negative breast cancer.

Infusions of Epstein-Barr virus (EBV)–specific cytotoxic T lymphocytes from healthy donors led to high response rates and significant extensions in overall survival for patients with rituximab-refractory EBV–associated lymphoproliferative disorders.

The PALOMA-3 trial examining a palbociclib regimen in HR+/HER2- breast cancer was halted after an independent panel determined it met the primary endpoint of improving progression-free survival.

The Senate has joined the House of Representatives in passing legislation to repeal the Sustainable Growth Rate (SGR) formula and replace it with the Medicare Access and CHIP Reauthorization Act of 2015 (HR 2).

For further insight into the evolving role of expanded mutation analysis in mCRC, OncLive interviewed Marwan G. Fakih, MD, the director of Gastrointestinal Medical Oncology at City of Hope.

The FDA has granted a breakthrough therapy designation to rucaparib as a treatment for women with BRCA-mutated advanced ovarian cancer who have received at least two prior lines of platinum-based chemotherapy.

The FDA has granted an accelerated approval to an oral formulation of deferasirox (Jadenu) for the treatment of patients aged 2 and older with chronic iron overload due to multiple blood transfusions.

The FDA has updated the label for abiraterone acetate plus prednisone to include significant overall survival data from the final analysis of the phase III COU-AA-302 study.

An sNDA for the full approval of carfilzomib (Kyprolis) as a treatment for patients with relapsed multiple myeloma has been granted a priority review by the FDA.
The phase III HELIOS study examining ibrutinib in combination with bendamustine and rituximab has been unblinded following the demonstration of a significant extension in progression-free survival in patients with CLL or SLL.

The FDA has approved dinutuximab in combination with interleukin-2, GM-CSF, and 13-cis-retinoic acid as a frontline therapy for pediatric patients with high-risk neuroblastoma.

AbbVie has announced plans to acquire the blockbuster BTK inhibitor ibrutinib, through a $21 billion acquisition of Pharmacyclics.

The Nobel Prize winning director of the National Cancer Institute, Harold Varmus, MD, has tendered his resignation to pursue research interests in New York.

Carfilzomib doubled progression-free survival versus bortezomib in patients with relapsed multiple myeloma in the phase III ENDEAVOR trial.

Heterogeneity, which can result in treatment resistance, is commonly underestimated and misunderstood, representing an important area of future research.

While not appropriate for all patients with ER-positive breast cancer, neoadjuvant endocrine therapy could play an important role in select groups of women with comorbidities or those with ER-rich/luminal A disease.

With the evolution of treatment under way, OncLive interviewed three world-renowned experts in the field: Joanne L. Blum, MD, PhD, Adam M. Brufsky, MD, PhD, and Harold J. Burstein, MD, PhD.

Treatment with eribulin mesylate significantly extended overall survival compared with dacarbazine in patients with advanced soft tissue sarcoma.

In an interview with OncLive, Suzanne L. Topalian, MD, director of the Melanoma Program at the Johns Hopkins Sidney Kimmel Comprehensive Cancer Center, discussed the rapid advance of nivolumab and potential next-steps.